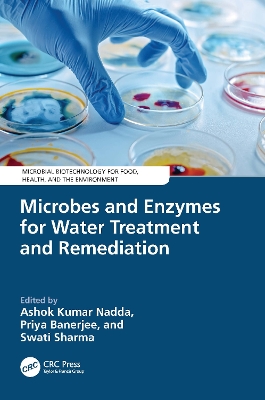
ibs

Microbes and Enzymes for Water Treatment and Remediation
The introduction of emerging contaminants through anthropogenic activities and industrial discharges has raised significant public health concerns worldwide. Various techniques, including bioremediation, have been explored for their effectiveness in removing pollutants from water bodies and effluents. Microorganisms, particularly bacteria and fungi, have emerged as promising candidates for bioremediation due to their abundance, diversity, and ability to thrive under various conditions. Microbes and Enzymes for Water Treatment and Remediation covers a range of topics, from the role of microorganisms and enzymes in efficient pollutant removal to recent advances in microbial immobilization and enzymatic systems for enhanced wastewater treatment. The book provides up-to-date insights into the potential of microbial and enzyme-based processes for wastewater treatment, addressing challenges and limitations while offering alternative methods for effluent treatment and water reclamation. It serves as a valuable resource for understanding the interplay between microbial, biological, and chemical components in the remediation of toxic aqueous pollutants, aiding both researchers and industrialists in advancing environmental stewardship efforts. Offers comprehensive coverage of emerging contaminants and their impact on public health. Provides in-depth exploration of bioremediation techniques utilizing microbial and enzymatic pathways. Addresses the limitations and challenges of the existing microbial and enzyme-based processes for wastewater treatment.
-
Curatore:
-
Editore:
-
Collana:Microbial Biotechnology for Food, Health, and the Environment
-
Anno:2024
-
Rilegatura:Hardback
Le schede prodotto sono aggiornate in conformità al Regolamento UE 988/2023. Laddove ci fossero taluni dati non disponibili per ragioni indipendenti da Feltrinelli, vi informiamo che stiamo compiendo ogni ragionevole sforzo per inserirli. Vi invitiamo a controllare periodicamente il sito www.lafeltrinelli.it per eventuali novità e aggiornamenti.
Per le vendite di prodotti da terze parti, ciascun venditore si assume la piena e diretta responsabilità per la commercializzazione del prodotto e per la sua conformità al Regolamento UE 988/2023, nonché alle normative nazionali ed europee vigenti.
Per informazioni sulla sicurezza dei prodotti, contattare productsafety@feltrinelli.it